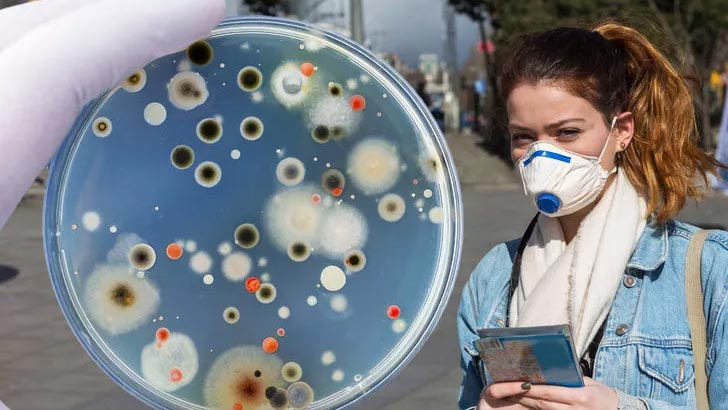
Maskeniz virüslere ne kadar dayanıklı? Maskeniz virüslere ne kadar dayanıklı?

Manchester Metropolitan Üniversitesi’nde emeritus tıbbi mikrobiyoloji profesörü olan Val Edwards-Jones, maskeler üzerine bir araştırma gerçekleştirdi. Deneyde birden farklı maske test edildi. Profesör, her bir maskeyi yüzüne taktı ve o esnada öksürük ya da hapşırık yoluyla küçük damlacıkları petri kabına bıraktı. İşte çarpıcı deneyin sonuçları.
Tıbbi mikrobiyoloji profesörü Val Edwards-Jones, maske testi için yüzünde maske takılıyken petri kaplarına öksürük veya hapşırık yoluyla damlacık bıraktı. Bu kaplar 48 saat boyunca inkübe edildi ve koloni sayıları sayıldı. Profesör test sonucu, bazı maskelerin havaya karışan damlacıkları tamamen engellediğini, bazı maskelerin ise yüzde 80’inin damlacıkları havaya karıştırdığını ortaya koydu. Peki, en etkili olan maske hangisiydi?
NEFES ALABİLEN KUMAŞTAN ÜRETİLEN MASKE
Nefes alabilen dokuma kumaşı spor ayakkabılarda kullanılan kumaşlara benzetiliyor. Yıkamak için önerilen sıcaklık ise 60 derece.
Koloni sayısı: 28
Damlacıkları engelleme yüzdesi: 57
İSVİÇRE ÜRETİMİ VİROBLOC MASKE
Koronavirüse karşı koruma etkisinin son derece yüksek olduğu test edilmiştir.
Koloni sayısı: 1
Damlacıkları engelleme yüzdesi: 98
KN95 MASKESİ
Yüzünüzün kıvrımlarına uyacak şekilde tasarlanan bu solunum maskesinde beş kat kumaş bulunur.
Koloni sayısı: 0
Damlacıkları engelleme yüzdesi: 100
YENİDEN KULLANILABİLİR BEZ MASKE
Yıkanabilir bez maskelerin elde yıkanması tavsiye ediliyor. Bir de çok uzun ömürlü olmadıklarının altını çizmek gerekiyor.
Koloni sayısı: 2
Damlacıkları engelleme yüzdesi: 97
VALFLİ DAYANIKLI NEOPREN SOLUNUM MASKESİ
Dayanıklılığı ne yazık ki düşük. Çünkü mikroplar valf deliğinden dışarı atılıyor.
Koloni sayısı: 30
Damlacıkları engelleme yüzdesi: 54
TEK KULLANIMLIK MASKE
Bu 3 katlı tek kullanımlık maskeler ıslandığında hızlı bir şekilde yenisiyle değiştirilmeli. Islanan tek kullanımlık maskelerin koruma etkisi azalır.
Koloni sayısı: 10
Damlacıkları engelleme yüzdesi: 85